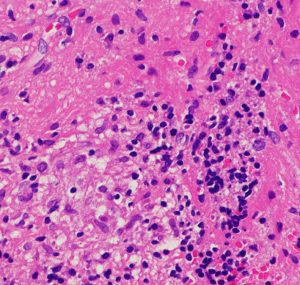

前頭葉白質浸潤・脳室壁に生じたジャーミノーマ
ジャーミノーマには好発部位というものがあります,神経下垂体,松果体,大脳基底核などですが,例外的な発生部位もあるので注意です。この例は,浸潤形態が脳室壁に沿う subependymal infiltrationという特徴からジャーミノーマと画像診断できるものです。
発見時に無症状で尿崩症もなにもなく,下垂体にも松果体にも腫瘍はありませんでした。
特に注意していただきたいのは,脳組織浸潤が主体で,germinomaとしての腫瘍塊を形成していないことです。正常脳組織内に腫瘍細胞とリンパ球が混在するという病理組織所見になります。
21歳男性で交通事故で偶然発見された両側前頭葉腫瘍です。


ガドリニウム増強では,前頭葉腫瘍というより,側脳室壁にベトベトくっついているような腫瘍です。germinoma特有のsubependymal infiltration像を示します。
大きな病院で内視鏡生検術が行われて,chronic cerebritisの病理診断で経過を見ることになりました。
生検後2ヶ月,セカンドオピニオンのために受診された時の画像です。腫瘍が縮小傾向にあります。入院中に行われた何度かのCT被曝の影響で,germinomaの退縮が生じたのだと判断しました。
germinomaの確定診断が必要だと判断して2度目の生検術を行いました。
脳梁部分にあった腫瘍の中心部の病理です。炎症細胞浸潤ですがほとんどがリンパ球であり,典型的なtwo-cell patternの所見を示します。
前頭葉深部白質の所見です。大型の疎な核を有する腫瘍細胞が白質内に散在性に浸潤 infiltrationしています。germinoma cells は,脳白質組織内を遊走 migration できる性質を有しています。

GFAP染色です。ある部位では腫瘍細胞が集簇 cluster して白質内に浸潤 invasion しています。germinomaは脳組織に浸潤する腫瘍です。ですから,GFAP養成組織の中に,腫瘍細胞が散在するという所見が得られる時もあります。この時には,GFAP陽性腫瘍であるからgerminomaではないという病理診断が下されてしまうこともあります。要注意です!!


左はICE化学療法 (IFO/CDDP/VP-16)前,右は1コース終了後です。腫瘍は顕著に縮小してgerminomaとして普通の化学療法反応性を示します。また,松果体と下垂体には腫瘍はありません。


ICEを3コース行なって腫瘍は完全消失して,前頭葉浮腫も消えました。その後に,全脳照射 25.2Gy/14分割を加えました。無症状で復職することができました。